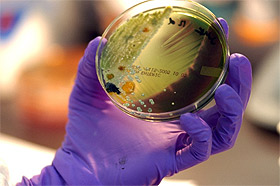
Picture of petri dish

News Archives - 2009
2009 URGO Summer Research Abstracts
Some Augsburg students are discovering that summer isn't just for working a few part-time jobs or perfecting one's beach volleyball technique. This summer, 32 students will conduct research through the URGO program. And they're not just studying algae growth. With their faculty mentors, this group is taking on topics like Minnesota's percussion legends, saliva, Augsburg's relationship with our neighbors, conspiracy fiction, aquatic insects, and the relationship between religiosity and depression...to name a few.
Some Augsburg students are discovering that summer isn't just for working a few part-time jobs or perfecting one's beach volleyball technique. This summer, 32 students will conduct research through the URGO program. And they're not just studying algae growth. With their faculty mentors, this group is taking on topics like Minnesota's percussion legends, saliva, Augsburg's relationship with our neighbors, conspiracy fiction, aquatic insects, and the relationship between religiosity and depression...to name a few.
URGO—the office of Undergraduate Research and Graduate Opportunity—provides summer research grants for students interested in graduate or professional study. The program encourages undergraduate students to conduct research by requiring an understanding of current questions in a field, the ability to collaborate with others, and the persistence necessary to meet the demands of graduate study.
Students are involved in research activities 40 hours per week for nine weeks. They also participate in weekly research roundtable discussions, submit weekly progress reports to the URGO office, and are required to present their findings at Augsburg's year-end Zyzzogeton festival. The 2009 URGO summer research abstracts are listed below.
Aybike Bakan with Jennifer Bankers-Fulbright (Dr. B.)
Biology
Dr. B has previously demonstrated that toxins from a human white blood cell, the eosinophil, stimulates the release of a major pro-inflammatory chemical, interleukin-6, from human lung surface (epithelial) cells. However, the human lung epithelial cells used in the previous experiments were from a tumor cell line. Although tumor cells are useful for preliminary testing, they may not accurately reflect what happens in a normal, non-tumor cell or tissue. Thus, the research question being asked by this project is: When normal human lung epithelial cells are treated with eosinophil toxins, is IL-6 specifically released?
Nick Blixt with Ralph Butkowski
Biology
The primary goal of this project is to improve and optimize the methods that we use to analyze aquatic insects' DNA. Previous URGO work demonstrated the ability to analyze aquatic insects' DNA for species identification using a recently-introduced process called "DNA barcoding." While barcoding worked well for the caddisfly taxa, it was marginally successful for other insect families. This indicates a need to optimize the barcoding process. This project will focus on several key steps in the barcoding process, especially in DNA isolation and the PCR amplification of the isolated DNA.
Anna Boyle with Garry Hesser
Political Science
The research will focus on one of, or a combination of, the following topics: (1) a general interpretation of the legislative history project for the purpose of informing and orienting my peers who are interested in public policy in Minnesota; (2) a focused historical analysis of a particular policy issue that promises to be increasingly significant in the near future, such as public transportation, health care, or anti-poverty strategies; (3) A political analysis of how and whether the critical policy and legislative process issues of the 1970's overlap with/are related to the critical policy issues and political processes of today.
RuthAnn Dohner with Jennifer Bankers-Fulbright
Biology
Asthmatics frequently have more (or more severe) "colds" than non-asthmatics, yet the reason for this is not clear. One hypothesis suggests that the inflammatory cells found in asthma patients' lungs cause damage to the epithelium (lining) of the lung, making it easier for cold viruses to gain a foothold. A second, non-exclusionary hypothesis states that cold viruses infect patients with and without asthma with the same frequency, but that the epithelial damage caused by the cold virus in asthmatics is longer lasting than in non-asthmatics. Epithelial repair inhibition caused by inflammatory cells and/or their secreted mediators present in asthmatics' lungs likely causes such phenomena. This research is designed to test the second hypothesis. When normal human lung epithelial cells are damaged (as by a cold virus), do proteins secreted by asthma-related inflammatory cells slow the healing process?
Dustin Dorsey with Chris Botanga
Biology
Professor Bill Capman (Augsburg College) recently observed that two different populations of Abutilon theophrasti (Velvetleaf) show two very distinct classes of interactions with Cuscuta pentagona (Field Dodder, a parasitic plant). One class is highly resistant to the parasite (resistant interaction) while the other class is highly susceptible (susceptible interaction). We hypothesize that these interactions are under genetic control, and we hope to investigate this by using different DNA fingerprinting approaches in an effort to identify molecular markers that are associated with host resistance or susceptibility phenotypes.
Katie Edelen by Dave Hanson
Chemistry
We will be exploring the degradation scheme or oxidative mechanism of isoprene and its role in ozone formation.
Jessica Fanaselle with Colin Irvine
English
I will investigate the digitization of research materials generally in order to understand why and how this process is done. Along with Dr. Irvine, and the Academic Liaison for Computing in the Humanities Division and Fine Arts Division, Scott Krenz, I will create three versions of Leopold's A Sand County Almanac with annotations linking to relevant secondary sources and the Leopold Papers (these will be decided and sorted primarily by Colin Irvine and another student researcher, Taylor Norman). The goal of this project is to discover which method is most conducive to undergraduate research and exploration.
Jessica Hilk with Anthony Clapp
Health and Physical Education
Will lower leg plyometric exercises increase vertical jumping ability in Division III collegiate volleyball players?
Benjamin Hoffman with Pavel Belik
Mathematics and Physics
Organic photovoltaic (solar) cells (as opposed to inorganic cells, such as those composed of crystalline silicon) have become an important research area due to their potential low manufacturing cost, and their flexibility and ease of manipulation. They currently suffer from low power conversion efficiency, i.e. the output of electric energy is still relatively small when compared to the input solar energy. We propose to study, implement, and perhaps extend the methods currently available in literature on the subject of optimizing this conversion efficiency from a mathematical modeling and computer simulation point of view. In particular, we intend to study, reproduce, and hopefully extend the results from a recent (2008) paper by University of Michigan researchers, "Photocurrent Generation in Nanostructured Organic Solar Cells," in which several structurally different morphologies of the materials in question are studied using numerical simulations and compared based on their solar-to-electric conversion efficiencies.
Eric Howe with Pavel Belik
Computer Science and Math
In this research we propose to extend Dr. Belik's work in the area of modeling the behavior of heat-shrinkable thin films after they have undergone a heat treatment. The student researcher(s) will work off a recently published paper by the mentor. On the most basic level, there will be the analysis and improvement of the numerical methods and optimization of their implementation in order to allow for larger-scale computations. Next, efforts will be made in extending the model from isotropic, homogenous materials (those that exhibit identical behavior in all material directions) to anisotropic ones, some of which have been used by 3M researchers (who originally motivated this research). Finally, we'll try extending the model to films that are composed of several layers of different materials. In all of these directions, we would like to secure the collaboration of 3M in order to validate the modeling results not only qualitatively (which has already been done), but also quantitatively.
Nick Hudson with Ben Stottrup
Physics
Two research questions will be investigated: (1) how can worm micelles be formed using similar micelle construction methods?; (2) After I have found a technique for correctly forming worm micelles, I will move on to how this micelle changes and reacts when two changes are introduced. The first of these changes is to add and increase the cholesterol within the lipid structure. The second change is to increase and decrease the pressure on the worm micelle.
James Kleason with David Crowe
Biology and Computer Science
How does the electrical activity of cells in the brain encode spatial relationships? We will focus on the activity of cells in the posterior parietal cortex.
Randall Krug with Arlin Gyberg
Biology and Chemistry
How can various stressors increase algae oil content? This is of important interest for biodiesel production via algae oil. This research will expand on previous studies, in which nutrient variations and growth inhibitors were found to be successful oil biosynthesis triggers. Successful studies will be confirmed and other potential stressors will be investigated. At this point, wild MN algae have been used and again will be primarily employed for this study. Other strains may be studied, if time permits.
Arianna Lofrano with William Capman
Biology
We will investigate the genetic basis of an apparent case of resistance to parasitic plants (dodder, Cuscuta pentagona) observed in certain individuals of the common agricultural weed (velvetleaf, Abutilon theophrasti). First, we wish to determine whether previously observed resistance to dodder exhibited by some individuals of velvetleaf is inheritable. Second, if initial studies indicate inheritable resistance, we wish to determine the genetic nature of the trait. Third, we wish to begin a search for genetic markers that correlate with resistance to dodder in velvetleaf plants.
Emily Merhar with robert tom
Studio Art
We will explore different terra sigillata colorants on three different clay bodies through multiple cultural dishwater and cutleries. This process will begin with the experimenting of terra sigillata colorants. Terra sigillata can be used to mask the surface of the pot with an inert layer, which effectively separates the pot from the glaze. Terra sigillata can also be used to introduce a reactive layer, which in conjunction with the glaze gives a range of colored textural, often decorative, effects that cannot be achieved by other means. By using three earthen clay bodies, this project will explore how the clay can affect these different ranges of colored textural and decorative effects can vary. The content of the ceramic pieces will be based on three different cultural environments around Augsburg College and Minneapolis: Somali, Hmong, and Hispanic. On site research will be conducted through visiting local stores, restaurants, and volunteer opportunities. Developing cultural competence will help in creating dishware that reflects culturally significant symbols, imagery, colors, shapes, and themes.
Juventino Meza Rodriguez with Paul C. Pribbenow
Sociology and Peace Studies
The project, tentatively entitled "Augsburg College Maps and Papers" will address the historical and contemporary relationship between Augsburg College and the immigrant communities that surround the college campus. The central thesis of the project is that more intentionality about who our neighbors are will provide a foundation for assessing how well we have served their needs in the past and for setting priorities for future engagement.
Therese Miller with Jennifer Bankers-Fulbright
Biology
Asthmatics frequently have more (or more severe) "colds" than non-asthmatics, yet the reason for this is not clear. One hypothesis suggests that the inflammatory cells found in asthma patients' lungs cause damage to the epithelium (lining) of the lung, making it easier for cold viruses to gain a foothold. A second, non-exclusionary hypothesis states that cold viruses infect patients with and without asthma with the same frequency, but that the epithelial damage caused by the cold virus in asthmatics is longer lasting than in non-asthmatics. Epithelial repair inhibition caused by inflammatory cells and/or their secreted mediators present in asthmatics' lungs likely causes such phenomena. This research is designed to test the second hypothesis. When normal human lung epithelial cells are damaged (as by a cold virus), do proteins secreted by asthma-related inflammatory cells slow the healing process?
Andrew Myers with Bob Stacke
Music
Marv Dahlgren and Elliot Fine are two Minnesotan percussion legends whose lives, careers, teachings, and experiences have and will continue to benefit the world of percussion. This research seeks to reveal their stories, history, and the teachings of Marv and Elliot in order to preserve their vast knowledge and anecdotes that the percussion world will benefit from.
Allison Nelson with Sandra Olmsted
Chemistry
Is the oxidation procedure from the Summer 2008 URGO "universal?" Particularly, what effect do ring-activating groups have on the rate and yield of the reaction compared to the "standard" toluene? Also, what is the nature of the copper ion species used in the oxidation protocol explored last summer and this spring? Specifically, which ions of Cu+, Cu2+, and Cu3+ is/are present? These are a few of the many questions raised throughout research conducted last summer through URGO. McNair student Adam Horkey is also collaborating.
Besty Norell with Dale Taylor
Music Therapy
Is there a significant difference between the changes in the SIgA (salivary immunoglobulin A) present in a person's saliva after a music therapy session versus the amount of change in SIgA present in a person's saliva after a music therapy session that does not involve music? We hypothesize that there is no difference.
Taylor Norman with Colin Irvine
English
The main objective of this project will be to create four similar, but essentially different, experiences of Aldo Leopold's A Sand County Almanac (ASCA) and the works and writing that preceded its publication. I will be responsible for two of these experiences—specifically creating a hypertext version of (ASCA) and a version organized around the "Contents" page of the book using the 3,000+ pages of primary source documents courtesy of the Aldo Leopold Foundation.
Katie Pendo with Dave Hanson
Biology and Chemistry
We propose to observe, over time, the volatile organic compounds that are consumed and produced by green algae used by SarTech for the purpose of biodiesel. A variety of exposure conditions will be explored and mass increase/decrease of the algae cultures will be quantified.
Melissa Robertson with David Crowe
Biology and Computer Science
We will investigate how the electrical activity of cells in the brain encodes spatial relationships. We will focus on the activity of cells in the posterior parietal cortex.
Natalie Sasseville with Jeremy Myers
Theology and Psychology
We would like to focus our research on the question: "How might Christian Theology inform the relationship between religiosity and anxiety/depression in adolescents and young adults?" Specifically, we are proposing a qualitative research project in practical theology—a branch of Christian theology that both investigates and applies knowledge found in theological investigation of socio-cultural issues and practices. In his book, The Teaching Ministry of Congregations, Richard Osmer, a professor at Princeton Theological Seminary, defines practical theology as "that branch of Christian theology that seeks to construct action-guiding theories of Christian praxis in particular social contexts." Our project will thus investigate the relationships between religiosity and anxiety/depression in adolescents and young adults in the context of Post-Modern America. Our theological investigation will involve describing and explaining psychological research findings in order to better understand, develop, and apply new practices in the Christian ministry.
Ruth Senum with Linda Stevens
Education
How does a teacher knowing student development and misconceptions of graph understanding contribute to conducting effective classroom discussions with students about graphs?
Mackenzie Shiell with Peter Ralston
Psychology
Professor Nicki Crick at the University of Minnesota is conducting a longitudinal research project investigating peer aggression and related behavioral and psychological adjustment in 4th grade children around the Minneapolis area. The research team will interview the participants and obtain questionnaires from teachers and parents to understand (among other things) depressed affect among children. Since I am interested in understanding how the parent-child relationship affects childhood depression, I propose four hypotheses that are separate from main research goals: (1) parents who score high on verbal hostility toward their child and use non-reasoning punishment will have children who score higher on depression; (2) parents who score high on parent-child connection and child regulation behaviors will have children who score low on depression; (3) parents who score low child-regulatory behaviors and high on intrusiveness will have children who score high on depression; (4) parents who score high on demanding child conformity and high on parental dignity/achievement will have children who score high on depression. Moreover, based on previous research, we expect gender differences to emerge such that daughters will be more influenced than sons.
John Singleton with Pavel Belik
Mathematics and Physics
Organic photovoltaic (solar) cells (as opposed to inorganic ones such as those based on crystalline silicon) have become an important research area due to their potential low manufacturing cost, flexibility, and ease of manipulation. They currently suffer from low power conversion efficiency, i.e., the output of electric energy is still relatively small when compared to the input solar energy. We propose to study, implement, and perhaps extend the methods currently available in literature on the subject of optimizing this conversion efficiency from a mathematical modeling and computer simulation point of view. In particular, we would like to extend a current 1-dimensional simulation to two dimensions in order to optimize the geometry of a particular interface between two layers of the organic solar cell. This research is motivated by the experimentalists in the area of chemical engineering, who are interested in knowing how to best design such cells.
Sam Smith with James Vela-McConnell
Sociology
This research will ask a variety of questions about the construction of identity in the online role-playing game World of Warcraft (WoW) in order to compare and contrast real-life models of identity construction and self-perception with the models observed in a virtual setting. We will investigate which similarities and differences with real-life presentation of self are observed in the presentation of users' virtual self. Also, what social factors of WoW (and more generally, the anonymity afforded by online communication) contribute to these perceived similarities or differences? In answering these questions, we hope to build a more detailed idea of what motivates and enthralls WoW players to develop such fully realized online personalities, eventually forming a general response that addresses these questions.
Colin Stanhill with Bob Cowgill
English and Film
What role has the genre of conspiracy fiction played in the development of postmodern literature? The main focus of this research will be on the novels Mumbo Jumbo by Ishmael Reed, Gravity's Rainbow by Thomas Pynchon, and Illuminatus! by Robert Shea and Robert Anton Wilson. Framing for these novels will be provided by the prototypical works Tlon, Uqbar, Orbis Tertius by Jorge Luis Borges and Ubik by Philip K. Dick as well as the later novels Foucault's Pendulum by Umberto Eco and Libra by Don DeLillo.
Adam Williams with David Matz
Psychology
Evolutionary psychologists claim that because men and women have faced different adaptive challenges in the areas of mate selection and reproduction, each has developed unique mate preferences (Buss, 2003). As is the case with other animal species, human beings attempt to showcase their positive attributes in order to attract a mate. Evolutionary psychologists have demonstrated that such displays actually do help to attract potential mates (Anderson, 1994). In the English language, there are some words that are used more frequently (high-frequency words) than others (low frequency words). Lower-frequency words are generally known by people with higher intelligence and could, therefore, be used as a display of intelligence (Miller, 2000). If the greater use of low-frequency words is indicative of intelligence and potential success, then potential mates should prefer those using more low-frequency words. My hypothesis is that someone using lower-frequency words will be considered more attractive than someone who uses higher-frequency words.
Breann Woelfel with Ralph Butkowski
Biology
Stoneflies are considered to be the most sensitive indicators of environmental disturbance among aquatic insects. During the summer of 2008, URGO participants identified stoneflies in Rice Creek in Anoka County, Minnesota. This observation is especially important because stoneflies had not previously been documented in Rice Creek, and their presence suggests water quality in the creek may have improved, or that stoneflies were missed in past surveys. This project will survey reaches of Rice Creek and two tributaries for stoneflies and other indicator insects including caddisflies and mayflies. We propose to collect and document insect diversity from Rice Creek in stretches that have undergone restoration in 2005, and from two main tributaries, Coldwater Creek and Hardwood Creek. We will determine oxygen levels in the collection areas as a chemical indicator of water quality. Insect from the taxa of indicator species, stoneflies, mayflies, and caddisflies, will be characterized using a newly established method of species identification, called DNA barcoding. Barcoding from Minnesotan streams has not been previously reported, and our results will contribute to new information on the insect database, in addition to generating water quality information.
Shane Wyborny with Vivian Feng and Arlin Gyberg
Biology and Chemistry
How light intensity, color, and distance (which affect the rate of algae growth) are of significant concern for the eventual production of algae as an oil source for biodiesel production. This research will expand upon some initial ideas to determine the optimal conditions for rapid algae growth with respect to intensity, color, and distance. Studies will continue with wild algae although it time permits other strains will be investigated.